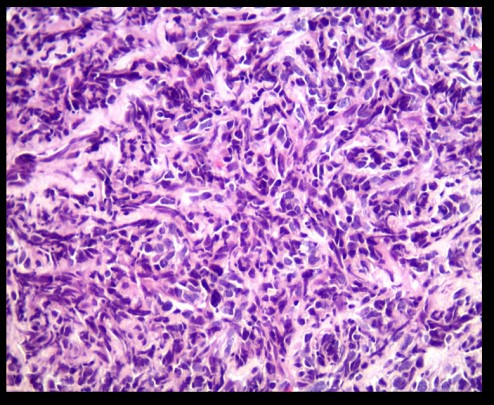
END3

La classification des néoplasies neuroendocriniens (NEN) diffère selon les systèmes organiques, elle cause actuellement une confusion considérable. Un cadre de classification uniforme des NEN dans n’importe quelle localisation anatomique peut réduire les incohérences et les contradictions entre les divers systèmes actuellement utilisés.
S. Lameche, KH. Bouzid Bendisari, A. Slimani, Service d’Anatomie et de Cytologie Pathologiques du CHU Issaad Hassani, Beni-Messous, Alger.
Date de soumission : 14 Décembre 2019.
Abstract: The classification of neuroendocrine neoplasms (NEN) differs between organic systems and is currently causing considerable confusion. A uniform NEN classification framework at any anatomical location can reduce inconsistencies between the various systems currently in use. The purpose of the classification suggested here is to enable pathologists and clinicians to manage their NEN patients in a consistent manner, while recognizing organ differences in terms of classification criteria, molecular biology, and prognostic factors. The proposed classification is based on a conference organized at the International Agency for Research on Cancer (IARC) in November 2017. The new classification is characterized by a distinction between differentiated neuroendocrine tumors (NETs), also referred to as carcinoid tumors in some systems, and poorly differentiated NECs, as they both share a common expression of neuroendocrine markers. This morphological subdivision into NET and NEC is confirmed by genetic evidence on specific anatomical sites as well as by clinical, epidemiological, and histological differences. NETs are classified as G1, G2 or G3 depending on the number of mitoses and/or the Ki-67 labeling index and/or the presence of necrosis; NECs are considered high grade malignancy by definition. We believe that this conceptual approach can form the basis of future classifications of NENs and will allow a better understanding of neuroendocrine neoplasms of different organs.
Keywords: NEN (neuroendocrine neoplasia), TNE (neuroendocrine tumor), NEC (neuroendocrine carcinoma), classification, organ.
Résumé : La classification des néoplasies neuroendocriniens (NEN) diffère selon les systèmes organiques, elle cause actuellement une confusion considérable. Un cadre de classification uniforme des NEN dans n’importe quelle localisation anatomique peut réduire les incohérences et les contradictions entre les divers systèmes actuellement utilisés. La classification suggérée ici a pour but de permettre aux pathologistes et aux cliniciens de gérer leurs patients atteints de NEN de manière cohérente, tout en reconnaissant les différences entre organes en termes de critères de classification, de biologie moléculaire et de facteurs pronostiques. La classification proposée repose sur une conférence organisée au Centre International de Recherche sur le Cancer (CIRC) en novembre 2017. Cette nouvelle classification se caractérise par une distinction entre les tumeurs neuroendocrines différenciées (TNE), également désignées tumeurs carcinoïdes dans certains systèmes, et les NEC (carcinome neuro-endocrine), carcinomes peu différenciés car ils partagent tous les deux une expression commune de marqueurs neuroendocriniens. Cette subdivision morphologique en TNE et NEC est confirmée par des preuves génétiques sur des sites anatomiques spécifiques, ainsi que par des différences cliniques, épidémiologiques et histologiques. Les TNE sont classées G1, G2 ou G3 en fonction du nombre de mitoses et/ou de l’indice de marquage Ki-67 et/ou de la présence de nécrose. Les NEC sont considérés comme de haut grade de malignité par définition. Nous pensons que cette approche conceptuelle peut constituer la base des prochaines classifications des NEN et permettra une meilleure compréhension des néoplasies neuroendocrines des différents organes.
Mots-clés : NEN (néoplasie neuro endocrine), TNE (tumeur neuro endocrine), NEC (carcinome neuro-endocrine), classification, organe.
Introduction
Les classifications pathologiques actuelles des néoplasmes neuroendocriniens (NEN) dans différents organes utilisent une gamme de terminologies et de critères spécifiques au siège, créant une confusion importante parmi les pathologistes et les thérapeutes. Le Centre International de Recherche sur le Cancer (CIRC), de l’Organisation Mondiale de la Santé (OMS), a lancé la cinquième édition de la classification OMS des tumeurs, publiée sous le titre de Blue Books de l’OMS, largement utilisé (http://whobluebooks.iarc.fr).
Un cadre de classification uniforme pour les NEN ; selon la localisation n’importe quel emplacement anatomique réduirait les incohérences et les contradictions entre les divers systèmes actuellement utilisés, permettant ainsi l’unification des concepts de classification, malgré les différences d’organes spécifiques en termes de critères de classification, de biologie moléculaire et de facteurs pronostiques. La classification proposée ici a pour but de permettre aux pathologistes et aux cliniciens de gérer leurs patients atteints de NEN de manière cohérente et de faciliter les comparaisons entre les différentes entités entrant dans cette catégorie de néoplasmes.
La classification des NEN proposée désigne par le terme de tumeur neuroendocrine (TNE) une famille de néoplasmes bien différenciés dont le potentiel de métastaser ou d’envahir les tissus adjacents dépend du site et du type de tumeur, ainsi que de son grade ; le terme NEC indique clairement une histologie maligne et un comportement biologique de haut grade.
Dans certains sites, tels que l’hypophyse et la parathyroïde, la grande majorité des TNE présente un risque très faible de comportement métastatique (d’où la terminologie « adénome » utilisée dans ces sites).
Dans d’autres, comme le pancréas et l’intestin grêle, la plupart des TNE se comportent de manière maligne.
Classification proposée
Les NEN sont relativement rares et comprennent un groupe hétérogène de tumeurs caractérisées par la présence de granules neurosécrétoires caractéristiques en ME et présentant typiquement une histologie et un profil immunohistochimique caractéristiques. Leur incidence dans la population générale varie en fonction de la localisation anatomique spécifique [1]. Il a été largement reconnu que :
- Les NEN apparaissent dans presque tous les sites anatomiques, y compris les paraganglions, et sont répartis dans tout le corps, dans tous les types d’organes, ainsi que dans les tissus mous,
- Les NEN situés sur divers sites sont d’origine épithéliale ou neuronale / neuro-ectodermique et partagent des signatures morphologiques et d’expression protéique majeures en fonction de la différenciation,
- Les NEN expriment un spectre variable de protéines, partagées avec leurs homologues cellulaires normaux à des localisations anatomiques spécifiques, notamment des marqueurs de différenciation neuroendocrinienne générale (tels que la chromogranine A, la chromogranine B et la synaptophysine), ainsi que des marqueurs spécifiques au site, tels que des hormones et des facteurs de transcription,
- La terminologie et les critères des systèmes de classification existants varient considérablement d’un site à l’autre, des données fiables étayant les systèmes de classement de certains sites anatomiques (par exemple : poumon, tube digestif, pancréas) ; mais pas d’autres (par exemple : sein, thyroïde, parathyroïde).
- Le terme NEN englobe à la fois les TNE bien différenciées et les NEC peu différenciées, car elles partagent les mêmes caractéristiques histologiques, immunophénotypiques et neuroendocriniennes ultrastructurales. Cependant, les preuves génétiques sur des sites anatomiques spécifiques confirment la double subdivision morphologique qui distingue les NEC peu différenciées des TNE bien différenciées,
- Bien que leurs caractéristiques histologiques se chevauchent, leur inclusion dans un seul cadre de classification peut faussement donner à penser que des TNE bien différenciées et des NEC peu différenciées sont des néoplasmes étroitement apparentés. dans la plupart des organes où ces familles de néoplasmes ont été étudiées. Les données suggèrent qu’elles ne sont pas biologiquement étroitement liées [2]. En outre, pour avoir différents degrés d’agressivité biologique et des réponses différentes au traitement médical, les TNE et les CEN ont des facteurs de risque, des prédispositions héréditaires, des relations avec la néoplasie non-NE différentes, et une génétique sous-jacente. Ceci est bien établi au niveau du poumon et du tube digestif, décrites ci-dessous, mais encore limitées dans d’autres organes.
Le groupe d’experts a identifié six principaux points de discussion :
- Le site anatomique ;
- Définition de la catégorie de tumeur ;
- Définition de la famille de la tumeur ;
- Définition du type de tumeur ;
- Définition des sous-types de tumeur ;
- Procédure de classification de la tumeur.
- Le site anatomique
Il est reconnu que chaque site anatomique a sa propre particularité et ses caractéristiques cliniques et pathologiques, qui constituent souvent la base des systèmes de classification histologique.
Les caractéristiques anatomiques spécifiques au site doivent être prises en compte lors de la conception d’un système de classification commun afin d’éviter toute confusion éventuelle.
- Définition de la catégorie de tumeur
Il a été proposé et convenu d’adopter le terme de « néoplasme neuroendocrinien (NEN) », comme un terme englobant toutes les classes de tumeurs avec une différenciation neuroendocrine prédominante, comprenant des formes différenciées et peu différenciées. Compte tenu des multiples sources anatomiques (structures neuronales, organes endocriniens et/ou cellules neuroendocrines), la morphologie et l’expression de marqueurs de différenciation neuroendocrine (générale et spécifique) ont été reconnues comme des caractéristiques clés définissant ces néoplasmes à n’importe quel site anatomique spécifique.
Il a été reconnu que l’expression des marqueurs neuroendocriniens peut varier en fonction du site anatomique et du degré de différenciation, et que différents marqueurs neuroendocriniens généraux permettant de définir la différenciation neuroendocrine sont actuellement utilisés dans différents systèmes organiques (par exemple, les chromogranines).
- Définition de la famille de tumeur
Il a été proposé et convenu que deux familles (ou classes) de NEN épithéliaux soient reconnues, bien différenciées et peu différenciées. Il a en outre été convenu d’adopter des critères morphologiques classiques cytologiques / histologiques pour la définition de la différenciation (Tableau 1).
Il a été reconnu que les deux familles peuvent ne pas exister dans tous les sites anatomiques et que leur prévalence relative varie également considérablement selon le site d’origine.
Il a été proposé et accepté que la famille bien différenciée soit désignée « tumeur neuroendocrine (TNE) » et la famille peu différenciée « carcinome neuroendocrinien ».
Il existe des localisations de l’organisme où presque tous les NEN sont des TNE (par exemple, l’intestin grêle, les ovaires, la parathyroïde, l’hypophyse), et dans d’autres organes, les NEC sont prédominants (par exemple, le poumon, le côlon).
Comme il s’agit principalement d’une classification de NEN d’origine épithéliale, il a également été suggéré de considérer les paragangliomes (c’est-à-dire les NEN d’origine non épithéliale), comme une troisième famille de NEN.
- Définition du type de tumeur
Les types de tumeur (Tableau 1) représentent les entités de diagnostic au sein des familles décrites ci-dessus : pour certaines d’entre elles, il s’agit actuellement du même nom que le nom de famille avec l’ajout d’un site (par exemple, TNE pancréatique), mais cela peut différer substantiellement (par exemple, tumeur carcinoïde, cancer du poumon à petites cellules). Les types de tumeurs indépendants sont identifiés par leurs propres codes CIM-O (http://codes.iarc.fr), qui doivent être conservés jusqu’à leur révision dans le cadre de la classification OMS des tumeurs.
- Définition du sous-type de tumeur
Les sous-types de tumeur (variantes) peuvent être définis morphologiquement ou par d’autres critères, et certains peuvent avoir leur propre code CIM-O.
Catégorie tumorale
Il a été proposé et convenu que les néoplasmes bien différenciés (TNE) devraient être classés en trois grades : G1, G2 et G3 (Tableau 1), correspondant à un bas grade, grade intermédiaire et haut grade. Dans certains organes, la nomenclature actuelle reflète intrinsèquement le grade (par exemple, poumon et thymus, où les tumeurs carcinoïdes sont G1 et les tumeurs carcinoïdes atypiques sont G2) et, par conséquent, les pratiques de déclaration actuelles ne spécifient pas séparément le grade. Il n’est pas nécessaire de classer NEC car ils sont toujours de haut grade.
Le nombre de mitoses doit généralement être exprimé en mitoses par mm² de surface, idéalement comptée jusqu’à 10 mm² pour assurer la précision.
Dans les NEN pulmonaires et pancréatiques, il est courant d’exprimer le nombre de mitoses dans une zone de 2 mm². En pratique, la disponibilité des tissus peut restreindre les zones disponibles pour le comptage. Il peut également être judicieux de spécifier le nombre de mitoses comptées dans la surface totale évaluée pour chaque cas (c’est-à-dire, X mitoses en Y mm²), l’index mitotique des cellules Ki-67 effectué sur les zones de marquage les plus intenses « hots spots d’au moins 0,4 mm² », en utilisant un anticorps validé (à savoir, l’anticorps MIB1), la présence ou l’absence de nécrose, définie par des critères morphologiques. La nécrose peut être focale (ponctuée) ou diffuse (en carte géographique).
Il a été proposé et convenu que le compte rendu de l’anatomo-pathologiste :
- Indique clairement les paramètres utilisés pour le grading (index mitotique, indice de marquage Ki-67 [%] et nécrose) ;
- La nomenclature tumorale spécifique au site selon les classifications actuelles de l’OMS soit indiquée en premier lieu, et le nouveau cadre de classification standard uniforme soit ajouté entre parenthèses, c’est-à-dire (NEN-OMS 2018).
Points supplémentaires
Les NEN dans certains sites anatomiques sont en outre caractérisés sur la base de leur production de substances bioactives (hormones peptidiques ou bioamines), et dans un certain nombre de sites anatomiques, il existe des NEN cliniquement fonctionnels dans lesquels un syndrome hormonal ou paranéoplasique peut être la manifestation clinique dominante du néoplasme.
Il a été reconnu que la détection des produits de sécrétion, soit dans le sérum, soit par immunohistochimie pour doser les cellules tumorales, pouvait être pertinente pour la classification (c.-à-d. dans l’hypophyse), pour le pronostic (comme dans les insulinomes pancréatiques), ou pour la corrélation avec les symptômes cliniques chez certains patients.
Cependant, étant donné la diversité des différentes substances bioactives produites dans les NEN situés à différents endroits, aucune recommandation générale pour les analyser ne peut être élaborée.
Il existe dans de nombreux sites anatomiques des néoplasmes présentant à la fois des éléments neuroendocriniens et non neuroendocriniens, qui peuvent être présents dans des populations cellulaires morphologiquement distinctes ou plus intimement mélangés.
Les éléments neuroendocriniens de ces néoplasmes « mixtes » ou « combinés » sont le plus souvent des CEN. Les composants non neuroendocriniens peuvent être des lignées glandulaires, squameuses ou autres. Ainsi des désignations telles que néoplasie mixte neuroendocrine-non neuroendocrine (MiNEN) sont proposées.
Tableau 1 (16) Titre du tableau ?
| Siège Catégorie | Famille | Type | Grading | Terminologie Actuelle |
| Poumon Néoplasmes Neuro- endocrines | Tumeurs neuro-endocrines | NET pulmonaire | G1 G2 | Carcinoïde typique Carcinoïde atypique |
| Carcinomes neuro-endocrines | Carcinome à petites cellules Carcinome à grandes cellules | Carcinome à petites cellules Carcinome à grandes cellules | ||
| Utérus (col Néoplasmes Et corps) neuro endocrines | Tumeurs neuro-endocrines | Tumeurs neuro-endocrines | G1 G2 G3 | Carcinoïde typique Carcinoïde atypique Carcinoïde atypique |
| Carcinomes neuro-endocrines | Carcinome à petites cellules Carcinome à grandes cellules | Carcinome à petites cellules Carcinome à grandes cellules | ||
| Pancréas Néoplasmes neuro endocrines | Tumeurs neuro-endocrines | NET pancréatique | G1 G2 G3 | PanNET G1 PanNET G2 PanNET G3 |
| Carcinome à petites cellules Carcinome à grandes cellules | Carcinome à petites cellules Carcinome à grandes cellules | |||
Implication de la classification selon le site à un site spécifique
Tractus gastro-intestinal et pancréas (3,4)
La classification NEN proposée actuellement (Tableau 1) repose en grande partie sur la classification récemment mise à jour par l’OMS pour les NEN pancréatiques [3,4]. Cette classification distingue les tumeurs NE pancréatiques bien différenciées (PanNET) et les carcinomes NE. La classification des TNE en trois grades (G1, G2 et G3) est basée sur la prolifération évaluée par l’index mitotique et l’index de prolifération Ki-67. La nécrose, bien que reconnue comme un facteur pronostique défavorable, n’est pas incluse dans les paramètres de classement. Une progression de G1 ou G2 NET à G3 peut se produire, à la fois dans une tumeur primitive et entre les sites de la maladie, en particulier au fil du temps, à mesure que la tumeur évolue cliniquement. Inversement, très rare est la progression de G3 NET vers NEC.
Dans le tractus gastro-intestinal, la classification des NEN a été mise à jour par l’OMS en 2019. Il a été proposé qu’un système à trois grades (G1 – G3) soit également adopté pour les TNE dans le tractus gastro-intestinal [2].
Cependant, la plupart des NEN de haut grade du tractus gastro-intestinal sont des NEC, avec des mutations dans TP53 et RB1. Dans le côlon, des mutations APC similaires à celles observées dans les adénocarcinomes, ne sont généralement pas rapportées dans les TNE.
Poumon (1,2,4)
Dans le poumon, les NEN sont actuellement classés en carcinoïde typique de faible grade, en carcinoïde atypique de grade intermédiaire et en carcinome pulmonaire à grandes cellules de haut grade (LCNEC), et carcinome pulmonaire à petites cellules (CPPC) [1,2,4]. L’utilisation de cette terminologie et des critères de l’OMS 2015, a été recommandée par une récente directive ENETS basée sur une revue systématique de la littérature et le consensus d’un groupe d’experts multidisciplinaire international et approuvée par l’Association internationale pour l’étude du cancer du poumon.
Le rôle principal du Ki-67 dans les NEN pulmonaires est de distinguer les carcinoïdes des LCNEC et des CPPC de haut grade. Ceci est particulièrement important dans les petites biopsies avec artefact, où les carcinoïdes peuvent être diagnostiqués à tort comme une CPPC.
Il est urgent de poursuivre les travaux sur ce sujet, à la fois sur la séparation des carcinoïdes typiques et des carcinoïdes atypiques ; et des carcinoïdes des LCNEC et des CPPC de haut grade.
La catégorie de carcinoïde atypique G3 dans le poumon n’est pas une entité validée et n’est pas reconnue dans la classification de l’OMS de 2015, bien que quelques études suggèrent l’existence de ces cas.
Hypophyse (3,7)
La classification actuelle de l’OMS ne comprend que les néoplasies bien différenciés classées comme adénomes ou carcinomes bien différenciés en fonction de la présence de métastases à distance et subdivisées en fonction de la production d’hormones.
Cependant, malgré la rareté de la propagation métastatique à distance, il est reconnu que ces tumeurs ont une incidence élevée d’invasion des tissus environnants. Comme récemment défini, « les tumeurs agressives avec invasion, et la croissance tumorale inhabituellement rapide, les récidives multiples malgré des thérapies optimales » entraînent une morbidité et une mortalité significatives.
Cependant, la classification de ces tumeurs en G1, G2 et G3 n’est actuellement pas possible sur la base des données disponibles. Les mitoses sont rares dans ces tumeurs et il n’existe aucune donnée sur la valeur du nombre de mitoses dans la classification actuelle. La nécrose étant rare, elle semble liée à la thrombose vasculaire.
Cavité nasale, larynx, trachée, cou et glande parotide (8,9)
Les néoplasmes neuroendocriniens épithéliaux de l’OMS, Head and Neck de 2016, sont classés en carcinomes neuroendocriniens bien différenciés (carcinoïde typique), moyennement différenciés (carcinoïde atypique) et peu différenciés (petites et grandes cellules). Dans la nomenclature proposée, sur la base d’une proposition récente, ils sont collectivement dénommés NEN (Tableau 1), avec des carcinomes bien différenciés (carcinoïde typique), et moyennement différenciés (carcinoïde atypique), et sont définis comme étant des TNE de grades 1 et 2, respectivement ; et les carcinomes neuroendocriniens peu différenciés en tant que NEC, SCNEC et LCNEC.
Glande thyroïde (3)
La grande majorité des NEN thyroïdiens sont des tumeurs des cellules C (cellules parafolliculaires), traditionnellement appelées « carcinome médullaire de la thyroïde » (CMT). Les CMT représentent actuellement 3 à 5% de tous les carcinomes de la thyroïde et se développent dans le cadre des syndromes MEN2 (néoplasie neuro-endocrine multiple de type 2) dans environ 30% des cas.
La plupart des CMT sont des TNE bien différenciées, basées sur l’expression de la calcitonine et du TTF-1, les NEC agressifs et peu différenciés représentent moins de 1% des CMT.
Parathyroïdes (3)
La classification actuelle comprend les néoplasies bien différenciés classées comme adénomes, adénomes atypiques ou carcinomes. Les carcinomes peu différenciés et agressifs correspondant aux NEC parathyroïdiennes sont extrêmement rares. Le diagnostic de malignité repose sur la mise en évidence d’une invasion vasculaire et une effraction complète de la capsule tumorale avec extension dans les tissus non néoplasiques environnants ou des métastases.
Glande mammaire (5)
Les NEN du sein sont rares et mal définis. Hormis de rares cas de carcinome à petites cellules, analogues à son homologue pulmonaire, la définition des NEN dans le sein varie considérablement, entraînant une incidence variable < 0,1%.
Appareil génito-urinaire et organes gynécologiques (10,11,12)
La classification 2016 de l’OMS des tumeurs de l’appareil urinaire et des organes génitaux masculins a introduit une nouvelle terminologie pour les TNE, avec des TNE bien différenciées, des LCNEC, des SCNEC et un paragangliome pour les NEN du rein, de la prostate et de la vessie. Les termes : carcinoïde, carcinoïde typique et atypique ne sont pas recommandés.
Les NEN sont rares dans l’appareil génital féminin. Ils sont plus fréquents dans l’ovaire, où la plupart sont cliniquement bénins, correspondent morphologiquement aux tumeurs carcinoïdes et apparaissent dans les kystes dermoïdes. Le col utérin est le site le plus fréquent.
La terminologie a été source de confusion dans le passé. Actuellement, la classification mise à jour 2014 de l’OMS a introduit des changements dans la terminologie des NEN . Dans le col utérin, le corps et la vulve, les catégories de TNE de faible grade, et de NEC de haut grade, sont utilisées et correspondent au TNE et au NEC au niveau du système actuellement proposé. Les carcinoïdes et les carcinoïdes atypiques sont considérés comme synonyme de TNE de faible grade à petite cellule et les grandes cellules NEC sont synonymes de NEC de haut grade. Ces termes remplacent les différentes catégories de tumeurs carcinoïdes, carcinoïdes atypiques et NEC à petites cellules et NEC à grandes cellules utilisé dans WHO 2003.
Glande surrénale et paragangliomes (13,14)
Des tumeurs qui dérivent de la crête neurale peuvent apparaitre dans tout l’organisme. Lorsqu’elles sont situées dans la médullo-surrénale, elles sont désignées sous l’appellation phéochromocytomes, ailleurs elles sont appelées paragangliomes en relation avec le système sympathique et parasympathique. En ce qui concerne le cadre de classification proposé, tous ces néoplasmes sont considérés comme bien différenciés et donc TNE.
Les phéochromocytomes et les paragangliomes sont très similaires sur le plan histologique mais l’évolution clinique est variable. La majorité des patients sont guéris après chirurgie et seule une minorité de cas métastasient.
Cependant ils doivent être considérés comme potentiellement malins et de nombreuses classifications ont été proposées pour prédire le comportement de ces néoplasies. Des systèmes de classification ont utilisé des caractéristiques histologiques et des critères biochimiques ou immunohistochimiques ; mais dans la nouvelle édition de l’OMS sur les tumeurs endocrines, ces scoring n’ont pas été validés.
Les deux plus récents travaux sont ceux de Thompson et de Kimura. Thompson a proposé un scoring du phéochromocytome de la glande surrénale (PASS )(13) basé sur 12 critères histologiques (8 critères attribuant 2 points et 4 critères marquant 1 point) pour un score total de 20. Un score de 4 ou plus indiquerait un comportement clinique défavorable de la tumeur. Kimura a proposé un système de scoring pour phéochromocytome et paragangliome surrénalien (GAPP) (14) sur la base de caractéristiques histologiques, le marquage Ki-67 et le dosage des catécholamines. Ce qui a conduit à distinguer trois grades : bien différencié, moyennement différencié et peu différencié ; ce qui correspond au cadre de la classification proposée. L’immunohistochimie du SDHB avait potentiellement une valeur supplémentaire dans la prédiction des métastases.
Revêtement cutané (15)
Le NEN cutané primitif est le carcinome à cellules de Merckel (MCC) c’est un néoplasme de haut grade peu différencié qui serait classé avec les carcinomes neuro-endocrines dans le cadre de la classification proposée. Ni le paramètre de prolifération ni la présence de nécrose ne sont formellement nécessaires
pour son statut d’un cancer de haut grade. Le facteur pronostique principal est la taille de la tumeur.
Les NEC cutanés primitifs à grandes cellules autres que le MCC ont été rapportés, mais ils représentent probablement des carcinomes des glandes sudoripares avec différenciation neuroendocrinienne.
Figure1 : TNE bien différenciée G1
 Figure 2 : TNE bien différenciée grade2
Figure 2 : TNE bien différenciée grade2
Figure 3 :carcinome neuro-endocrine

Figure 4 :TNE grade1 ki estimé à 2%.

Figure 5 :TNE grade 2 ki estimé à 12%.

Figure 6 : TNE grade 3 Ki estimé à 25%.

Figure 7 :CNEKi estimé à 90%.
Conclusion
les TNE représentent un groupe original de tumeurs dont le diagnostic et la classification reposent sur des critères morphologiques plutôt que sur des propriétés sécrétoires ou sur une origine embryologique commune. Leur diagnostic histopathologique est de difficulté variable, il nécessite fréquemment l’utilisation de techniques immunohistochimiques. Leur pronostic, souvent difficile à déterminer, est fonction de critères macroscopiques et histologiques, mais aussi de la qualité du traitement initial.
Il faut se réjouir des progrès rapides effectués dans la qualité et la précision de la classification des tumeurs endocrines. Ces progrès débouchent sur une meilleure prise en charge des patients sans y ajouter des complexités inutiles et préjudiciables.
Liens d’intérêts : Les auteurs déclarent ne pas avoir de liens d’intérêts.
Photos et illustrations : Service d’Anatomie et de Cytologie Pathologiques, CHU Issaad Hassani, Beni-Messous, Alger.
Bibliographie :
- Kloppel G. Neuroendocrine Neoplasms: Dichotomy, Origin and Classifications. Visc Med. 2017;33:324–30
- Travis WDBE, Burke AP, Marx A, Nicholson AG. WHO Classification of Tumours of the Lung, Pleura, Thymus and Heart. 4th ed. Bosman FTJE, Lakhani SR, Ohgaki H, editors. Lyon: International Agency for Research on Cancer; 2015. 412 p. 16.
- Lloyd RV, Osamura RY, Klöppel G, Rosai J. WHO Classification of Tumours of Endocrine Organs. 4th ed. Lyon: International Agency for Research on Cancer; 2017. 355 p.
- Asa SL, Mete O. Endocrine pathology: past, present and future. Pathology. 2018;50:111–8.
- Lakhani SREI, Schnitt SJ, Tan PY, van de Vijver MJ. WHO classification of tumours of the breast. 4th ed. Lyon: International Agency for Research on Cancer; 2012. 240 p.
- Nagtegaal ID1, Odze RD1, Klimstra D1, Paradis V1, Rugge M1, Schirmacher P1, Washington KM1, Carneiro F1, Cree IA1; WHO Classification of Tumours Editorial Board.The 2019 WHO classification of tumours of the digestive system Histopathology. 2019 Aug 21.
- Asa SL, Casar-Borota O, Chanson P, Delgrange E, Earls P, Ezzat S, et al. From pituitary adenoma to pituitary neuroendocrine tumor (PitNET): an International Pituitary Pathology Club proposal. Endocr Relat Cancer. 2017;24:C5–8 .
- Williams MD, Tischler AS. Update from the 4th edition of the World Health Organization classification of head and neck tumours: paragangliomas. Head Neck Pathol 2017;11:88–95.
- Klöppel G, Franchi A, Matias-Guiu X. Neuroendocrine Neoplasms, Olfactory Neuroblastomas and Paragangliomas of the Head and Neck. Cardesa A, Slootweg PJ, Gale N, Franchi A, editors. Pathology of the head and neck. 2nd ed. Berlin: Springer; 2016. p. 515–38.
- Moch HHP, Ulbright TM, Reuter VE. WHO classification of tumours of the urinary system and male genitalorgans. Bosman FTJE, Lakhani SR, Ohgaki H, editors. Lyon: International Agency for Research on Cancer; 2016. 356 p.
- Epstein JI, Amin MB, Beltran H, Lotan TL, Mosquera JM, Reuter VE, et al. Proposed morphologic classification of prostate cancer with neuroendocrine differentiation. Am J Surg Pathol. 2014;38:756–67.
- Howitt BE, Kelly P, Mc Cluggage WG. Pathology of Neuroendocrine Tumours of the Female Genital Tract. Curr Oncol Rep. 2017;19:59.
- Thompson LD. Pheochromocytoma of the Adrenal gland Scaled Score (PASS) to separate benign from malignant neoplasms: a clinico-pathologic and immunophenotypic study of 100 cases. Am J Surg Pathol. 2002;26:551–66. 107.
- Kimura N, Takayanagi R, Takizawa N, Itagaki E, Katabami T, Kakoi N, et al. Pathological grading for predicting metastasis in phaeochromocytoma and paraganglioma. Endocr Relat Cancer. 2014;21:405–14.
- Goto K, Anan T, Nakatsuka T, Kaku Y, Sakurai T, Fukumoto T, et al. Low-Grade Neuroendocrine Carcinoma of the Skin (Primary Cutaneous Carcinoid Tumor) as a Distinctive Entity of Cutaneous Neuroendocrine Tumors: A Clinicopathologic Study of 3 Cases With Literature Review. Am J Dermatopathol. 2017;39:250–8.
- Rindi G1, Klimstra DS2, Abedi-Ardekani B3, Asa SL4, Bosman FT5, Brambilla E6, Busam KJ2, de Krijger RR7, Dietel M8, El-Naggar AK9, Fernandez-Cuesta L3, Klöppel G10, McCluggage WG11, Moch H12, Ohgaki H3, Rakha EA13, Reed NS14, Rous BA15, Sasano H16, Scarpa A17, Scoazec JY18, Travis WD2, Tallini G19, Trouillas J20, van Krieken JH21, Cree IA2A common classification framework for neuroendocrine neoplasms: an International Agency for Research on Cancer (IARC) and World Health Organization (WHO) expert consensus proposal Mod Pathol. 2018 Dec;31(12):1770-1786. doi: 10.1038/s41379-018-0110-y. Epub 2018 Aug 23.



























